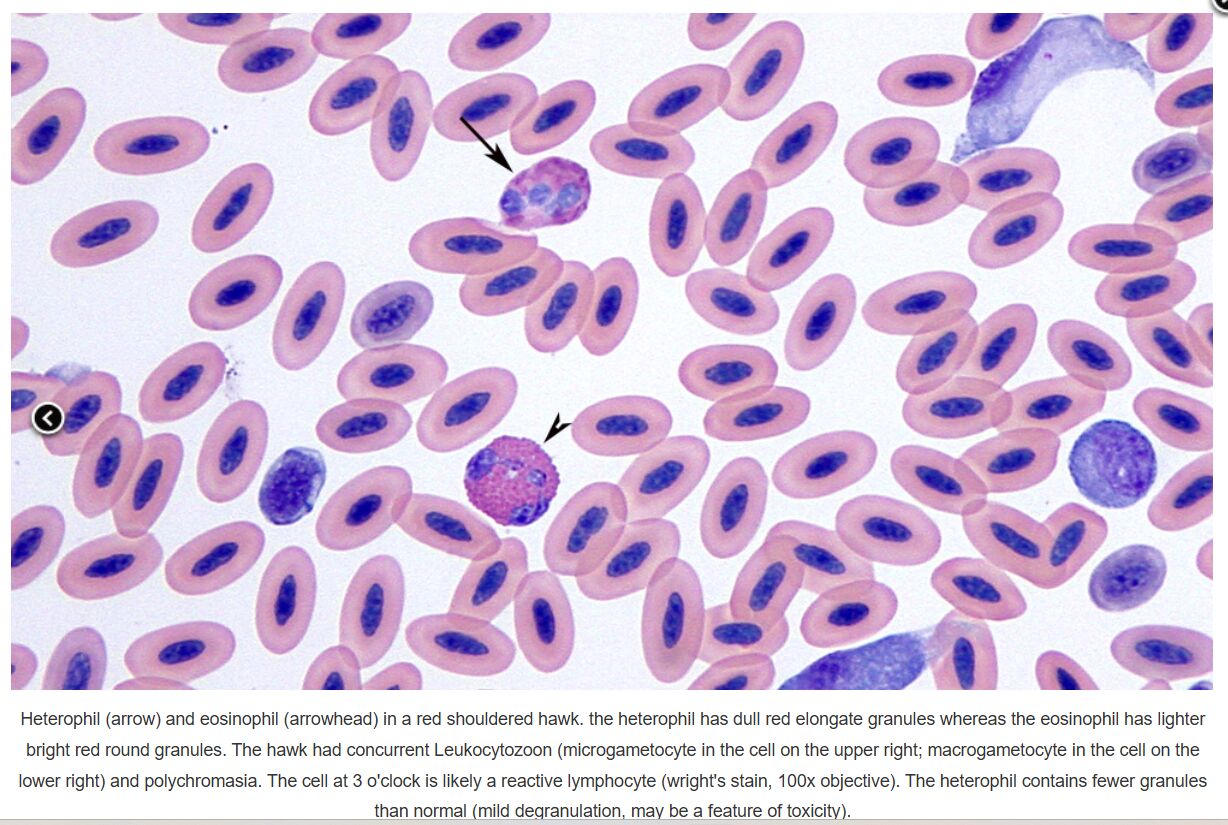
68596292d6e2e.jpg

17.多數鳥類和爬蟲類的異嗜球(heterophil)因染色特性,必須和那種血球加以區別?
(A)嗜中性球
(B)嗜酸性球
(C)嗜鹼性球
(D)單核球
答案:登入後查看
統計: A(251), B(959), C(76), D(76), E(0) #855517
統計: A(251), B(959), C(76), D(76), E(0) #855517